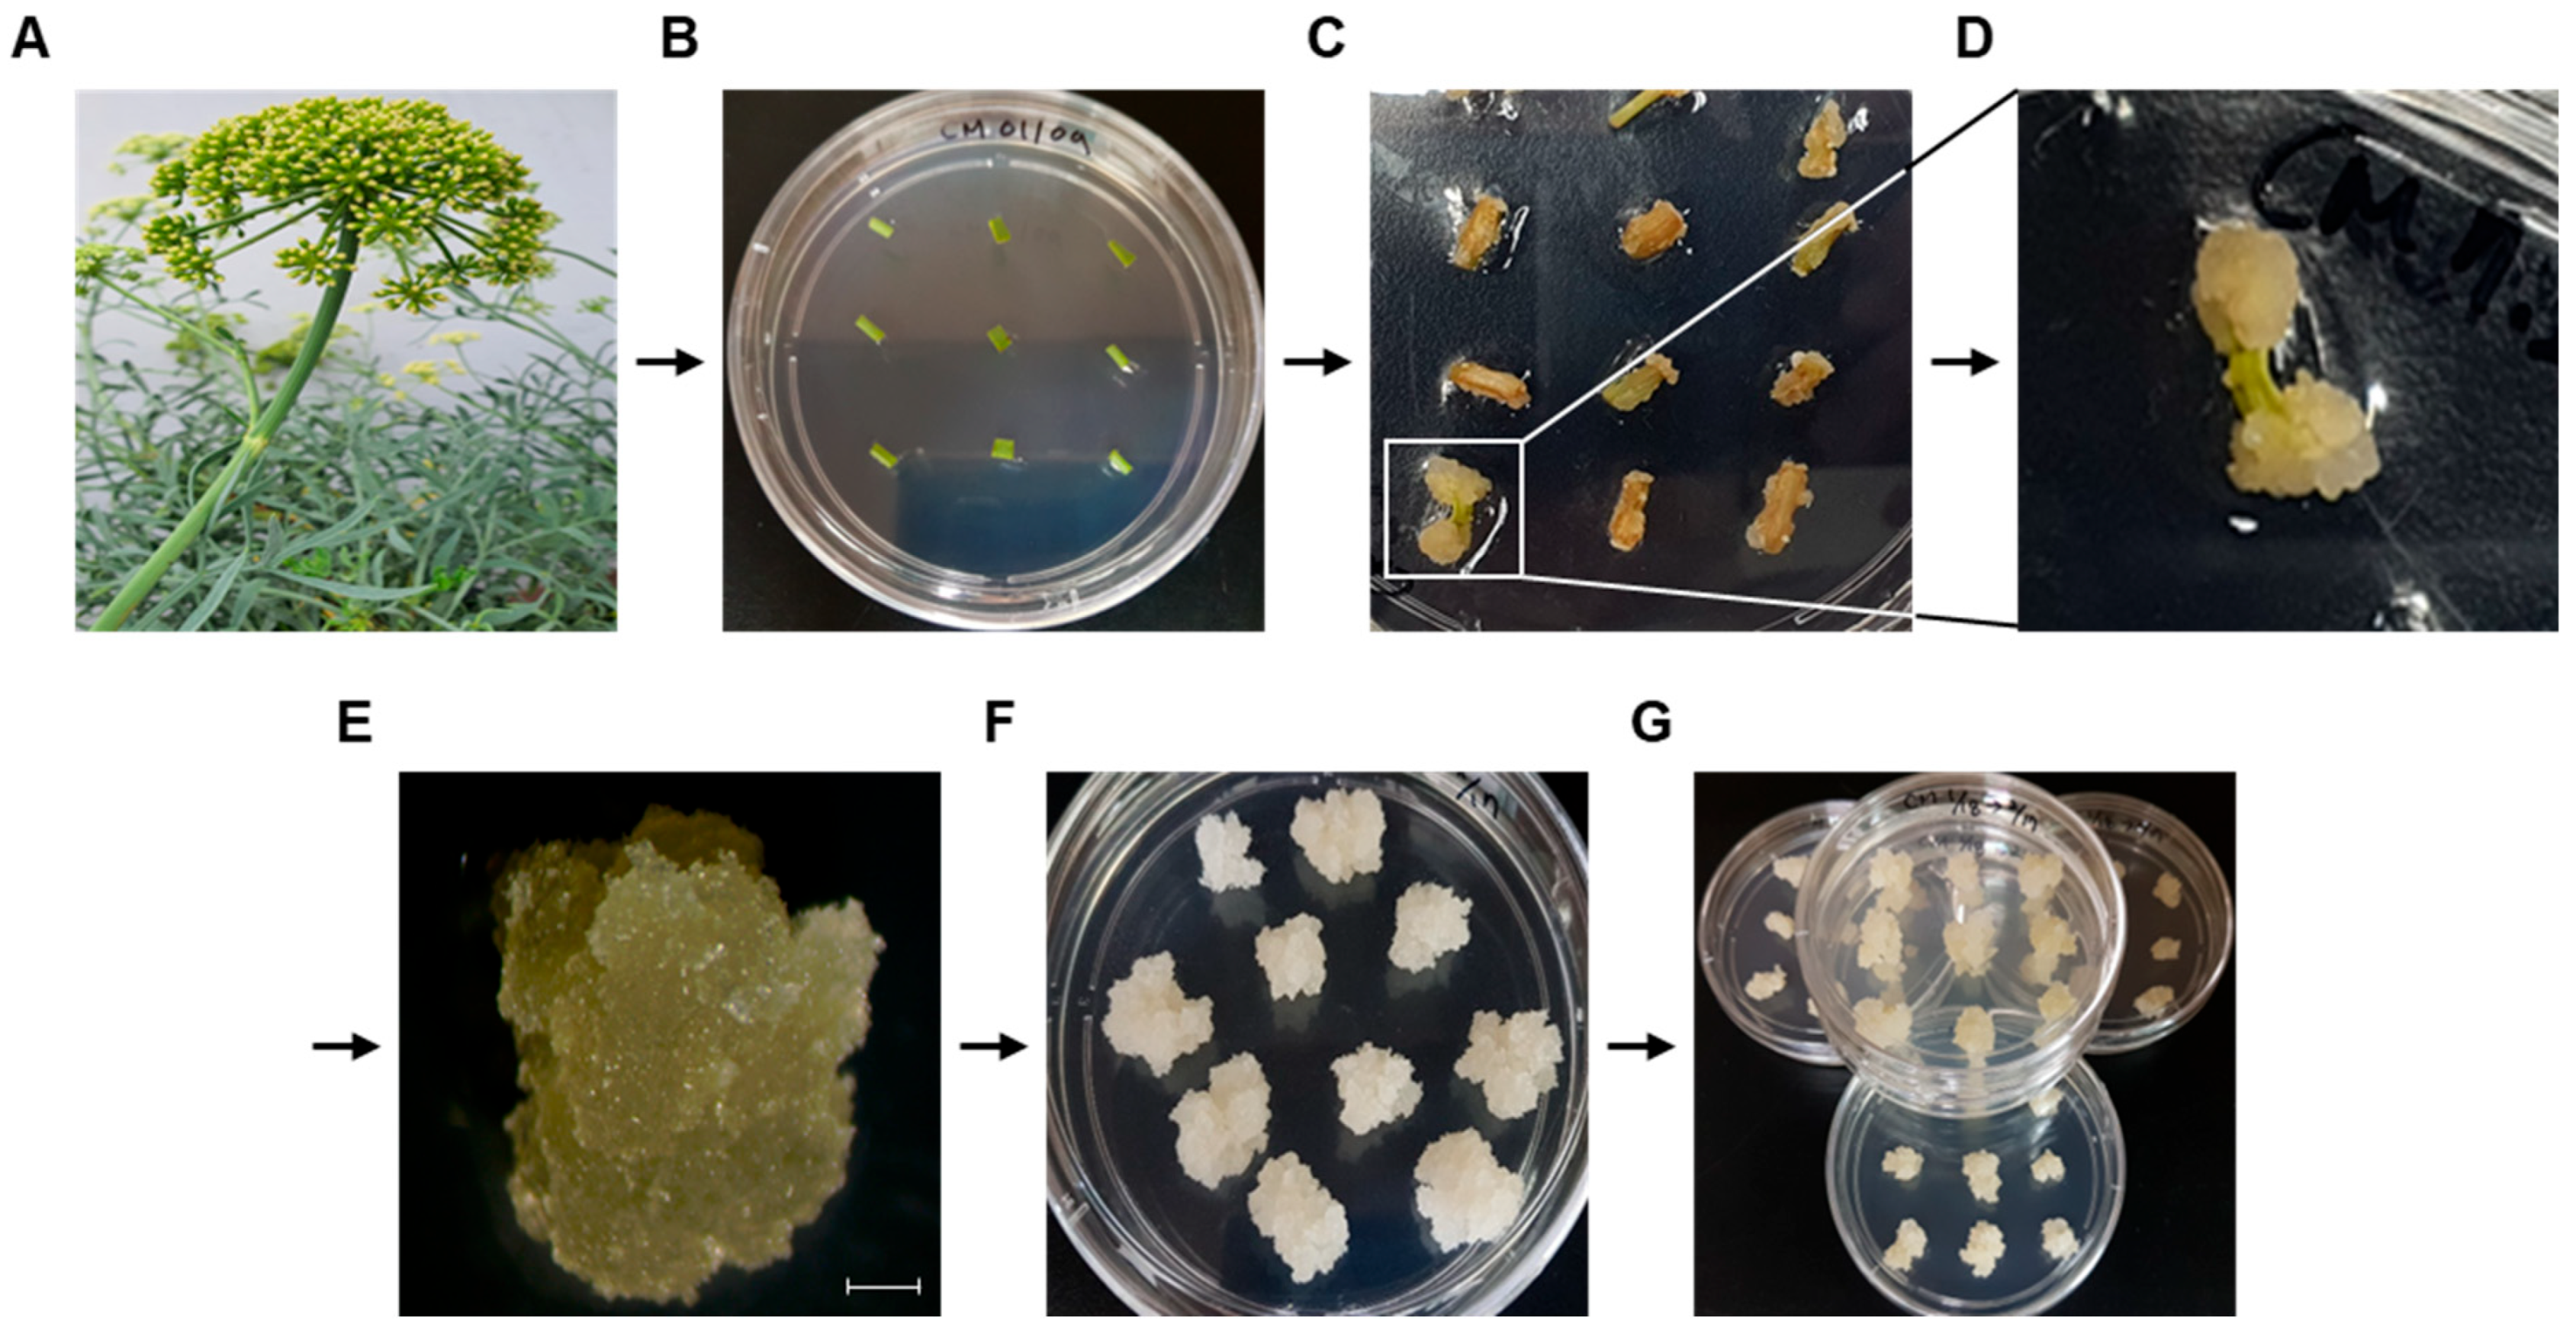
Biomolecules 15 01157 g001 Biomolecules 15 01157 g001

The Role of miRNA167 in Skin Improvement: Insight from Extracellular Vesicles Derived from Rock Samphire (Crithmum maritimum)
Abstract
1. Introduction
2. Materials & Methods
2.1. Callus Induction of Crithmum Maritimum (C. maritimum) and Suspension Culture
2.2. Isolation of Extracellular Vesicles (EVs) from Callus of C. maritimum
2.3. Transmission Electron Microscope (TEM) Imaging
2.4. Western Blot Analysis
2.5. Cell Culture
2.6. WST-1 Assay for Cell Viability
2.7. In Vitro Wound Healing Assay
2.8. Immunofluorescence (IF)
2.9. Quantitative Reverse-Transcription PCR (qRT-PCR)
2.10. Small RNA-Sequencing
2.11. Transfection of miRNA Mimics
2.12. Statistical Analysis
3. Results
3.1. Induction of Callus from C. maritimum
3.2. Isolation and Characterization of Extracellular Vesicles (EVs) from Callus of C. maritimum
3.3. Effect of Cm-callus EVs on Wound Healing and Skin Regeneration in Human Fibroblasts
3.4. Enrichment of tae-miR167c-5p in Cm-callus EVs
3.5. Effect of miR167 from Cm-callus EVs on Wound Healing and Skin Regeneration in Human Fibroblasts
3.6. PPP3R2 Could be a Target of miR167
4. Discussion
5. Conclusions
Supplementary Materials
Author Contributions
Funding
Institutional Review Board Statement
Informed Consent Statement
Data Availability Statement
Conflicts of Interest
References
- Flowers, T.J.; Colmer, T.D. Salinity tolerance in halophytes*. New Phytol. 2008, 179, 945–963. [Google Scholar] [CrossRef]
- Mzoughi, Z.; Majdoub, H. Pectic polysaccharides from edible halophytes: Insight on extraction processes, structural characterizations and immunomodulatory potentials. Int. J. Biol. Macromol. 2021, 173, 554–579. [Google Scholar] [CrossRef]
- Zengin, G.; Aumeeruddy-Elalfi, Z.; Mollica, A.; Yilmaz, M.A.; Mahomoodally, M.F. In vitro and in silico perspectives on biological and phytochemical profile of three halophyte species—A source of innovative phytopharmaceuticals from nature. Phytomedicine 2018, 38, 35–44. [Google Scholar] [CrossRef]
- Radman, S.; Mastelić, L.; Ljubenkov, I.; Lazarevski, S.; Politeo, O.; Podrug, R.; Prga, I.; Čorić, I.; Popović, M.; Bratinčević, M.V.; et al. Sea Fenel (Crithmum maritimum L.) Flowers as an Emerging Source of Bioactive Compounds Pol. J. Food Nutr. Sci. 2024, 74, 221–231. [Google Scholar]
- Generalić Mekinić, I.; Blažević, I.; Mudnić, I.; Burčul, F.; Grga, M.; Skroza, D.; Jerčić, I.; Ljubenkov, I.; Boban, M.; Miloš, M.; et al. Sea fennel (Crithmum maritimum L.): Phytochemical profile, antioxidative, cholinesterase inhibitory and vasodilatory activity. J. Food Sci. Technol. 2016, 53, 3104–3112. [Google Scholar] [CrossRef] [PubMed]
- Subha, D.; Harshnii, K.; Madhikiruba, K.G.; Nandhini, M.; Tamilselvi, K.S. Plant derived exosome-like Nanovesicles: An updated overview. Plant Nano Biol. 2023, 3, 100022. [Google Scholar] [CrossRef]
- O’Brien, K.; Breyne, K.; Ughetto, S.; Laurent, L.C.; Breakefield, X.O. RNA delivery by extracellular vesicles in mammalian cells and its applications. Nat. Rev. Mol. Cell Biol. 2020, 21, 585–606. [Google Scholar] [CrossRef] [PubMed]
- Bongiovanni1, L.; Andriessen, A.; Wauben, M.H.M.; Nolte-‘t Hoen, E.N.M.; Bruin, A. Extracellular Vesicles: Novel Opportunities to Understand and Detect Neoplastic Diseases. Vet. Pathol. 2021, 58, 453–471. [Google Scholar] [CrossRef]
- Wang, Y.; Wang, J.; Ma, J.; Zhou, Y.; Lu, R. Focusing on Future Applications and Current Challenges of Plant Derived Extracellular Vesicles. Pharmaceuticals 2022, 15, 708. [Google Scholar] [CrossRef]
- Ju, S.; Mu, J.; Dokland, T.; Zhuang, X.; Wang, Q.; Jiang, H.; Xiang, X.; Deng, Z.-B.; Wang, B.; Zhang, L.; et al. Grape Exosome-like Nanoparticles Induce Intestinal Stem Cells and Protect Mice from DSS-Induced Colitis. Mol. Ther. 2013, 21, 1345–1357. [Google Scholar] [CrossRef] [PubMed]
- Alzahrani, F.A.; Khan, M.I.; Kameli, N.; Alsahafi, E.; Riza, Y.M. Plant-Derived Extracellular Vesicles and Their Exciting Potential as the Future of Next-Generation Drug Delivery. Biomolecules 2023, 13, 839. [Google Scholar] [CrossRef] [PubMed]
- Gu, S.; Jin, L.; Zhang, F.; Sarnow, P.; Kay, M.A. The biological basis for microRNA target restriction to the 3′ untranslated region in mammalian mRNAs. Nat. Struct Mol. Biol. 2009, 16, 144–150. [Google Scholar] [CrossRef] [PubMed]
- Dong, Q.; Hu, B.; Zhang, C. microRNA and Their Roles in Plant Development. Front. Plant Sci. 2022, 13, 824240. [Google Scholar] [CrossRef]
- Saiyed, A.N.; Vasavada, A.R.; Kaid Johar, S.R. Recent trends in miRNA therapeutics and the application of plant miRNA for prevention and treatment of human diseases. Futur. J. Pharm Sci. 2022, 8, 24. [Google Scholar] [CrossRef] [PubMed]
- Wu, M.F.; Tian, Q.; Reed, J.W. Arabidopsis microRNA167 controls patterns of ARF6 and ARF8 expression, and regulates both female and male reproduction. Development 2006, 133, 4211–4218. [Google Scholar] [CrossRef] [PubMed]
- Liu, X.; Huang, S.; Xie, H. Advances in the regulation of plant development and stress response by miR167. Front. Biosci. 2021, 26, 655–665. [Google Scholar] [CrossRef]
- Díez-Sainz, E.; Milagro, F.I.; Aranaz, P.; Riezu-Boj, J.I.; Lorente-Cebrián, S. MicroRNAs from edible plants reach the human gastrointestinal tract and may act as potential regulators of gene expression. J. Physiol. Biochem. 2024, 80, 655–670. [Google Scholar] [CrossRef]
- Philip, A.; Ferro, V.A.; Tate, R.J. Determination of the potential bioavailability of plant microRNAs using a simulated human digestion process. Mol. Nutr. Food Res. 2015, 59, 1962–1972. [Google Scholar] [CrossRef]
- Islam, W.; Waheed, A.; Naveed, H.; Zeng, F. MicroRNAs Mediated Plant Responses to Salt Stress. Cells 2022, 11, 2806. [Google Scholar] [CrossRef]
- Gharat, S.A.; Shaw, B.P. Novel and conserved miRNAs in the halophyte Suaeda maritima identified by deep sequencing and computational predictions using the ESTs of two mangrove plants. BMC Plant Biol. 2015, 15, 301. [Google Scholar] [CrossRef]
- de Sena Brandine, G.; Smith, A.D. Falco: High-speed FastQC emulation for quality control of sequencing data. F1000Research 2019, 8, 1874. [Google Scholar] [CrossRef] [PubMed]
- Martin, M. Cutadapt removes adapter sequences from high-throughput sequencing reads. EMBnet. J. 2011, 17, 10–12. [Google Scholar] [CrossRef]
- Langmead, B.; Trapnell, C.; Pop, M.; Salzberg, S.L. Ultrafast and memory-efficient alignment of short DNA sequences to the human genome. Genome Biol. 2009, 10, R25. [Google Scholar] [CrossRef]
- Moraga, C.; Sanchez, E.; Ferrarini, M.G.; Gutierrez, R.A.; Vidal, E.A.; Sagot, M.F. BrumiR: A toolkit for de novo discovery of microRNAs from sRNA-seq data. GigaScience 2022, 11, giac093. [Google Scholar] [CrossRef]
- Griffiths-Jones, S.; Grocock, R.J.; van Dongen, S.; Bateman, A.; Enright, A.J. miRBase: microRNA sequences, targets and gene nomenclature. Nucleic Acids Res. 2006, 34, D140–D144. [Google Scholar] [CrossRef]
- Camacho, C.; Coulouris, G.; Avagyan, V.; Ma, N.; Papadopoulos, J.; Bealer, K.; Madden, T.L. BLAST+: Architecture and applications. BMC Bioinform. 2009, 10, 421. [Google Scholar] [CrossRef]
- Dai, X.; Zhuang, Z.; Zhao, P.X. psRNATarget: A plant small RNA target analysis server (2017 release). Nucleic Acids Res. 2018, 46, W49–W54. [Google Scholar] [CrossRef]
- Díez-Sainz, E.; Aranaz, P.; Amri, E.-Z.; Riezu-Boj, J.I.; Lorente-Cebrián, S.; Milagro, F.I. Plant miR8126-3p and miR8126-5p Decrease Lipid Accumulation Through Modulation of Metabolic Genes in a Human Hepatocyte Model That Mimics Steatosis. Int. J. Mol. Sci. 2024, 25, 1721. [Google Scholar] [CrossRef]
- Cho, J.H.; Hong, Y.D.; Kim, D.H.; Park, S.J.; Kim, J.S.; Kim, H.-M.; Yoon, E.J.; Cho, J.-S. Confrmation of plant-derived exosomes as bioactive substances for skin application through comparative analysis of keratinocyte transcriptome. Appl. Biol. Chem. 2022, 65, 8. [Google Scholar] [CrossRef]
- Midekessa, G.; Godakumara, K.; Ord, J.; Viil, J.; Lättekivi, F.; Dissanayake, K.; Kopanchuk, S.; Rinken, A.; Andronowska, A.; Bhattacharjee, S.; et al. Zeta Potential of Extracellular Vesicles: Toward Understanding the Attributes that Determine Colloidal Stability. ACS Omega 2020, 5, 16701–16710. [Google Scholar] [CrossRef]
- Pochapski, D.J.; dos Santos, C.C.; Leite, G.W.; Pulcinelli, S.H.; Santilli, C.V. Zeta Potential and Colloidal Stability Predictions for Inorganic Nanoparticle Dispersions: Effects of Experimental Conditions and Electrokinetic Models on the Interpretation of Results. Langmuir 2021, 37, 13379–13389. [Google Scholar] [CrossRef] [PubMed]
- Öztürk, K.; Kaplan, M.; Çalış, S. Effects of nanoparticle size, shape, and zeta potential on drug delivery. Int. J. Pharm. 2024, 666, 124799. [Google Scholar] [CrossRef]
- Tang, X.R.; Lei, S.-Y.; Zhang, Q.; Liu, Y.-Y.; Wu, H.; Cao, A.; Wang, H. How big nanoparticles carry small ones into cells: Actions captured by transmission electron microscopy. Colloids Surf. B Biointerfaces 2025, 245, 114272. [Google Scholar] [CrossRef]
- Rennick, J.J.; Johnston, A.P.R.; Parton, R.G. Key principles and methods for studying the endocytosis of biological and nanoparticle therapeutics. Nat. Nanotechnol. 2021, 16, 266–276. [Google Scholar] [CrossRef]
- Hoshyar, N.; Gray, S.; Han, H.; Bao, G. The effect of nanoparticle size on in vivo pharmacokinetics and cellular interaction. Nanomedicine 2016, 11, 673–692. [Google Scholar] [CrossRef]
- Prabhakar, U.; Maeda, H.; Jain, R.K.; Sevick-Muraca, E.M.; Zamboni, W.; Farokhzad, O.C.; Barry, S.T.; Gabizon, A.; Grodzinski, P.; Blakey, D.C. Challenges and Key Considerations of the Enhanced Permeability and Retention Effect for Nanomedicine Drug Delivery in Oncology. Cancer Res. 2013, 73, 2412–2417. [Google Scholar] [CrossRef]
- Kunhorm, P.; Chaicharoenaudomrung, N.; Noisa, P. Cordycepin-induced Keratinocyte Secretome Promotes Skin Cell Regeneration. In Vivo 2023, 37, 574–590. [Google Scholar] [CrossRef]
- Lee, Y.I.; Lee, S.G.; Ham, S.Y.; Jung, I.H.; Suk, J.M.; Lee, J.H. Exploring the Safety and Efficacy of Organic Light-Emitting Diode in Skin Rejuvenation and Wound Healing. Yonsei Med. J. 2024, 65, 98–107. [Google Scholar] [CrossRef]
- Leyane, T.S.; Jere, S.W.; Houreld, N.N. Cellular Signalling and Photobiomodulation in Chronic Wound Repair. Int. J. Mol. Sci. 2021, 22, 11223. [Google Scholar] [CrossRef] [PubMed]
- Cargnello, M.; Roux, P.P. Activation and Function of the MAPKs and Their Substrates, the MAPK-Activated Protein Kinases. Microbiol. Mol. Biol. Rev. 2011, 75, 50–83. [Google Scholar] [CrossRef]
- Lin, Y.; Song, Y.; Zhang, Y.; Shi, M.; Hou, A.; Han, S. NFAT signaling dysregulation in cancer: Emerging roles in cancer stem cells. Biomed. Pharmacother. 2023, 165, 115167. [Google Scholar] [CrossRef]
- Manabe, T.; Park, H.; Minami, T. Calcineurin-nuclear factor for activated T cells (NFAT) signaling in pathophysiology of wound healing. Inflamm. Regen. 2021, 41, 26. [Google Scholar] [CrossRef]

| Sample | # Total Reads | # Mapped Reads | |||
|---|---|---|---|---|---|
| miRNA * | rRNA † | tRNA † | ncRNA † (Other) | ||
| Cm-callus EVs | 4,787,527 | 10,194 | 647,678 | 4900 | 3,284,785 |
| Putative Human Target Genes of tae-miR167c-5p (from. psRNATarget V2) | |||||
|---|---|---|---|---|---|
| Rank | Target Accession | Expectation | UPE | mRNA Target Aligned Fragment (5′-3′) | Inhibition |
| 1 | NM_147180|PPP3R2 | 3 | −1 | UUAUGUCAUGUUGGUAGCUUUA | Cleavage |
| 2 | NM_001122853|MYOZ3 | 3 | −1 | GAUGAUGAUGAUGGCAGCUUUA | Cleavage |
| 3 | NM_006830|UQCR11 | 3.5 | −1 | GUUGAUCAUGCUGGUGGCUUGG | Cleavage |
| 4 | NM_012479|YWHAG | 3.5 | −1 | AUGGAUCGUGUUGGUAUUUUCA | Cleavage |
| 5 | NM_015026|MON2 | 3.5 | −1 | UAUGAUCAUGCAGUUAGCUUCA | Translation |
| 6 | NM_080391|PTP4A2 | 4 | −1 | UCAGAGAAUGCUGGUAGCUUAA | Cleavage |
| 7 | NM_022340|ZFYVE20 | 4 | −1 | CAGGAUCGUGCUGGUAGCACCA | Cleavage |
| 8 | NM_003672|CDC14A | 4 | −1 | GGGAAUCAUGUUGACAGUUUUA | Cleavage |
| 9 | NM_006004|UQCRH | 4 | −1 | UUGGCUUAGGCUGGUAGCUUCU | Cleavage |
| 10 | NM_001089591|UQCRHL | 4 | −1 | UUGGCUUAGGCUGGUAGCUUCU | Cleavage |
Disclaimer/Publisher’s Note: The statements, opinions and data contained in all publications are solely those of the individual author(s) and contributor(s) and not of MDPI and/or the editor(s). MDPI and/or the editor(s) disclaim responsibility for any injury to people or property resulting from any ideas, methods, instructions or products referred to in the content. |
© 2025 by the authors. Licensee MDPI, Basel, Switzerland. This article is an open access article distributed under the terms and conditions of the Creative Commons Attribution (CC BY) license (https://creativecommons.org/licenses/by/4.0/).
Share and Cite
Jin, S.; Ku, C.; Kim, H.J.; Kim, J.-G.; Kim, S.H.; Han, H.; Kang, H.C.; Hwang, J.S.; Kim, M.J. The Role of miRNA167 in Skin Improvement: Insight from Extracellular Vesicles Derived from Rock Samphire (Crithmum maritimum). Biomolecules 2025, 15, 1157. https://doi.org/10.3390/biom15081157
Jin S, Ku C, Kim HJ, Kim J-G, Kim SH, Han H, Kang HC, Hwang JS, Kim MJ. The Role of miRNA167 in Skin Improvement: Insight from Extracellular Vesicles Derived from Rock Samphire (Crithmum maritimum). Biomolecules. 2025; 15(8):1157. https://doi.org/10.3390/biom15081157
Chicago/Turabian StyleJin, Soll, ChangHoe Ku, Hye Jin Kim, Jae-Goo Kim, Sang Hoon Kim, Heyjin Han, Hee Cheol Kang, Jae Sung Hwang, and Mi Jung Kim. 2025. "The Role of miRNA167 in Skin Improvement: Insight from Extracellular Vesicles Derived from Rock Samphire (Crithmum maritimum)" Biomolecules 15, no. 8: 1157. https://doi.org/10.3390/biom15081157
APA StyleJin, S., Ku, C., Kim, H. J., Kim, J.-G., Kim, S. H., Han, H., Kang, H. C., Hwang, J. S., & Kim, M. J. (2025). The Role of miRNA167 in Skin Improvement: Insight from Extracellular Vesicles Derived from Rock Samphire (Crithmum maritimum). Biomolecules, 15(8), 1157. https://doi.org/10.3390/biom15081157

